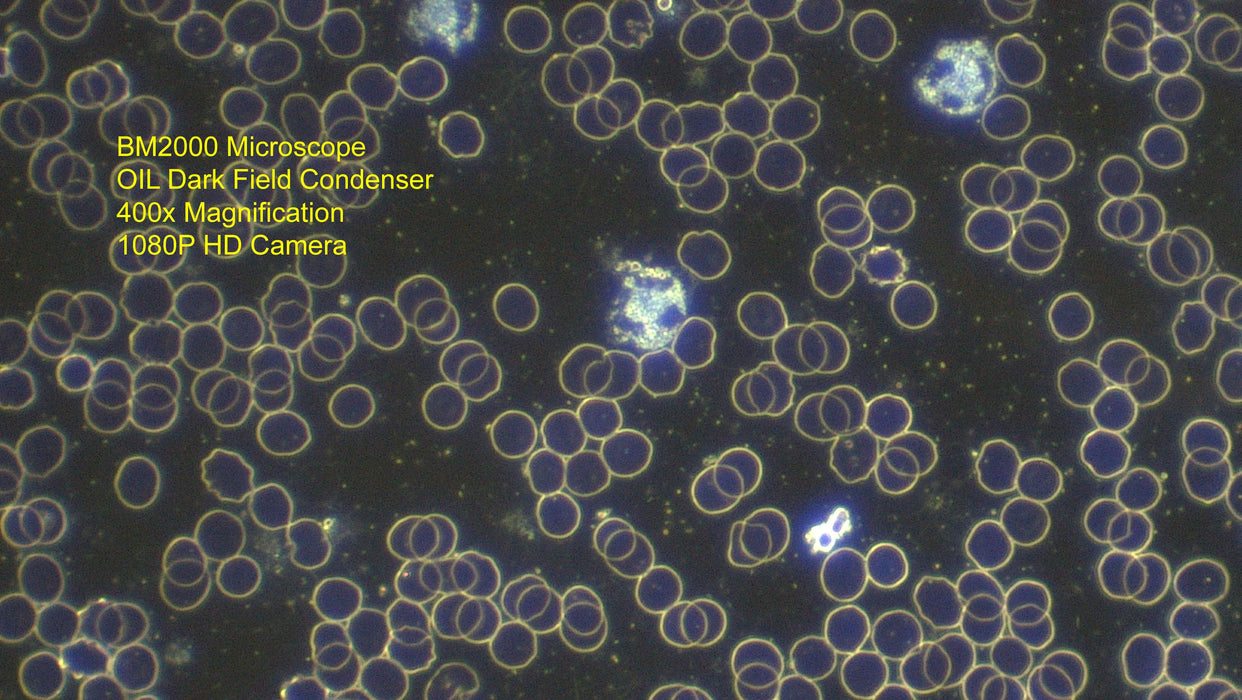

Beginners Live Blood Analysis Microscope
- Retail Price - $1995: Optico BM2000 Laboratory Microscope
- Retail Price - $445: OIL Dark Field Condenser
- Retail Price - $175: 30mm Centering Telescope Lens
- Retail Price - $1695: HDMI 1080P High-Definition Microscope Camera
- Retail Price - $145: ToupTek 0.5X Eyepiece Tube C-Mount Adapter
- Retail Price - $40: Duran Glass Blank Microscope Slides
- Retail Price - $35: Nikon Immersion Oil - 8cc
The Optico BM2000 is the top of the range ergonomically designed microscope, all the controls are easily accessible and comfortable when used specifically for extended periods of observation.
The included Infinity Plan Objectives produce a flat image across the field of view and perfect clarity. Also included is the standard bright field condenser enabling this microscope to be used for both bright field and dark field applications.
The 3W LED-LUX illumination system is the best solution to provide pure intense white light when using the higher magnification objectives, featuring the advanced XY stage design to ensure all the moving parts are concealed within the stage plate, as shown.
Specification of the Standard BM2000 Microscope:
- Optical System: Infinity Plan Achromatic Objective 4×, 10×, 20x, 40×
- Viewing Head: Seidentopf Trinocular Viewing Head, Inclined at 30°, 360° Rotatable, Interpupillary 48-75mm
- Eyepieces: WF10×/20
- Nosepiece: Backward Quadruple Nosepiece
- Focusing: Coaxial Coarse & Fine Adjustment, Fine Division 0.002mm, Coarse Stroke 37.7mm per Rotation, Fine Stroke 0.2mm per Rotation, Moving Range 22mm
- Stage: Rectangular 216×150mm, Cross Travel 78×54mm, Using Low-positioned X/Y Coaxial Control Knob.
- Condenser: Abbe Condenser NA1.25 with Aperture Diaphragm
- Illumination: 3W LED Illumination System
Please read before purchasing: Proper training required to set up and operate a Live Blood Analysis Microscope.
The Live Blood Analysis Microscope offered on our website is a highly specialised instrument that may be challenging to set up and use, particularly for those who have no prior experience with this type of microscope.
It is crucial that you are aware of the complexity of the live blood analysis microscope that you have purchased.
This type of microscope requires specific skills and knowledge that are beyond the scope of a typical microscope. It can be a highly advanced and intricate piece of equipment, which may be challenging to set up and operate without proper training and experience.
Therefore, we strongly urge you to be cautious and seek professional assistance from a qualified individual who has used this type of microscope before, or enrol in a live blood analysis course to understand how to use and setup this type of microscope.
Please take the time to understand the complexities of the microscope and the importance of professional training before attempting to use it. Doing so will not only help you to obtain accurate results, but it will also ensure the longevity and optimal performance of your microscope.